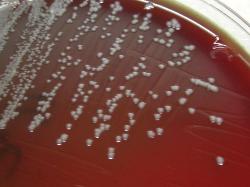

Legend: + positive 90-100%, - negative 90-100%, d positive 25-74% of strains
| Acinetobacter baumannii |
| A. baumannii colonies on Sheep Blood Agar |
| Acinetobacter baumannii, Gram-staining |
Taxonomy
Morphology
Cultural characteristics
Biochemical characters
Ecology
Pathogenicity
References
Phylum Pseudomonadota, Class Gammaproteobacteria, Order Pseudomonadales, Family Moraxellaceae, Genus Acinetobacter,
Acinetobacter baumannii Bouvet and Grimont 1986.
Acinetobacter baumannii Bouvet and Grimont 1986.
Gram-negative rods (0.9-1.6–1.5 x 1.5–2.5 μm), becoming spherical in the stationary
phase of growth. Grouped in pairs or chains. Aerobic. Non-motile but cells display
“twitching motility”. Non-sporulated.
phase of growth. Grouped in pairs or chains. Aerobic. Non-motile but cells display
“twitching motility”. Non-sporulated.
Colonies on tryptocasein soy agar are circular, convex, smooth, and slightly opaque
with entire margins and sometimes have a butyrous aspect. Nonhemolytic. Colonies
are 1.5-2.0 mm in diameter after 24 h and 3.0–4.0 mm in diameter after 48 h at 30 ºC.
Good growth occurs at 15-44 ºC. Strains may require methionine for growth on
minimal medium.
with entire margins and sometimes have a butyrous aspect. Nonhemolytic. Colonies
are 1.5-2.0 mm in diameter after 24 h and 3.0–4.0 mm in diameter after 48 h at 30 ºC.
Good growth occurs at 15-44 ºC. Strains may require methionine for growth on
minimal medium.
Isolated from human clinical specimens or the natural environment. The type strain
was isolated from urine.
was isolated from urine.
May be involved in nosocomial infections. It is an occasional cause of UTI, meningitis (post surgical), skin/soft tissue infections, and
others. One strain was isolated from the yolk sac of dead 1-day-age chicken (admin note).
others. One strain was isolated from the yolk sac of dead 1-day-age chicken (admin note).
- Elliot Juni and Kjell Bovre. Order IX Pseudomonadales Orla-Jensen 1921, Family II Moraxellaceae Rossau, Van Landschoot,
Gillis and De Ley 1991 In: Bergey’s Manual of Systematic Bacteriology, Second edition,Vol two, part B, George M. Garrity (Editor-in-
Chief), pp. 411-442. - Philippe J. M. Bouvet and Patrick A. D. Grimont. Taxonomy of the Genus Acinetobacter with the Recognition of Acinetobacter
baumannii sp. nov., Acinetobacter haemolyticus sp. nov., Acinetobacter johnsonii sp. nov., and Acinetobacter junii sp. nov. and
Emended Descriptions of Acinetobacter calcoaceticus and Acinetobacter lwoffii. Int J Syst Bacteriol April 1986 36:228-240. - Sofia Constantiniu, Angela Romaniuc, Luminiţa Smaranda Iancu, Raluca Filimon, Iuliana Taraşi. Cultural And Biochemical
Characteristics Of Acinetobacter spp. Strains Isolated From Hospital Units. The Journal Of Preventive Medicine 2004; 12 (3-4): 35-
42. - Anton Y. Peleg, Harald Seifert, znd David L. Paterson. Acinetobacter baumannii: Emergence of a Successful Pathogen. Clin
Microbiol Rev. 2008 July; 21(3): 538–582.
Positive results for catalase, beta-xylosidase, gamma-glutamyltransferase, utilization
of: L-arabinose, D-ribose, beta-alanine, DL-lactate, glutarate, L-aspartate, L-tyrosine,
ethanol, 2,3-butanediol, DL-4-aminobutyrate, L-phenylalanine, phenylacetate,
L-histidine, azelate, D-malate, L-leucine, trans-aconitate, L-arginine and L-ornithine.
Acid is produced from D-glucose by most strains. Citrate (Simmons) is utilized by
prototrophic strains. Auxotrophic strains utilize citrate when the medium is
supplemented with a growth factor.
Negative results for gelatin hydrolysis, nitrates reduction, oxidase, indole production,
H2S production, phenylalanine deaminase, amylase, DNase, beta-galactosidase,
and urease. Histamine is not utilized.
of: L-arabinose, D-ribose, beta-alanine, DL-lactate, glutarate, L-aspartate, L-tyrosine,
ethanol, 2,3-butanediol, DL-4-aminobutyrate, L-phenylalanine, phenylacetate,
L-histidine, azelate, D-malate, L-leucine, trans-aconitate, L-arginine and L-ornithine.
Acid is produced from D-glucose by most strains. Citrate (Simmons) is utilized by
prototrophic strains. Auxotrophic strains utilize citrate when the medium is
supplemented with a growth factor.
Negative results for gelatin hydrolysis, nitrates reduction, oxidase, indole production,
H2S production, phenylalanine deaminase, amylase, DNase, beta-galactosidase,
and urease. Histamine is not utilized.
(c) Costin Stoica

| Antibiogram |
| Encyclopedia |
| Culture media |
| Biochemical tests |
| Stainings |
| Images |
| Movies |
| Articles |
| Identification |
| Software |
| R E G N U M PROKARYOTAE |

|

| Back |